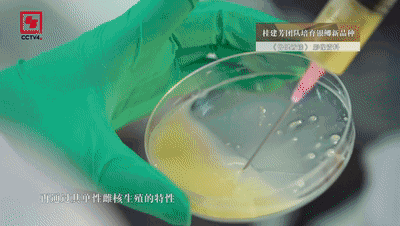

你知道吗?新中国成立初期,中国人每人平均一年才能吃上一条鱼。今天,中国人平均每人每周可以吃上一条重约0.9千克的鱼。
而我们吃到的每10条鲫鱼中,有7条都与桂建芳院士密不可分,他也因此被亲切地称为“鱼院士”。

△桂建芳院士
作为鱼类遗传育种学家,桂建芳40年专注研究“一条鱼”,让味美价廉的鲫鱼跃上千家万户的餐桌。如今,他步履不停,带领团队创制“无刺鱼”,希望为老百姓解决“吃鲫鱼挑刺儿难”的问题。
01
让老百姓吃得起鱼,他说到做到
1984年,桂建芳从武汉大学硕士毕业,从事鱼类染色体研究。在毕业答辩会上,他被时任中科院水生所遗传育种研究室主任的蒋一珪看中,应邀加入团队。“当时,蒋一珪先生在鲫鱼的育种方面起了个头,发现这种鱼可以单性雌核生殖,并培育出了异育银鲫。”
当时,中国农产品市场逐渐开放,鲫鱼的价格从一斤两三毛一下子提升到七八块,甚至将近十块一斤。刚毕业参加工作的桂建芳月工资收入六十多元,仅够买七八斤鱼,他下定决心:“要提高鱼类的产量和养殖面积,一定要让老百姓都吃得起鱼。”
次年,29岁的他开始研究银鲫,在全国大江、大河、大湖50多个样点,餐风饮露、不辞辛苦,取样4000多条,用分子标记进行遗传评价。
在包括桂建芳在内的水生所三代科学家的科研攻关下,他们连续培育出异育银鲫“中科3号”和“中科5号”等新品种,大大提高了鲫鱼养殖的产量和品质,让美味的鲫鱼跃上百姓桌。
“与高背鲫相比,‘中科3号’的生长速度提高了20%以上,它的身体比较瘦长,出肉率也比高背鲫提高了6%左右;‘中科5号’则抗病能力更强。”

目前,在我国鲫鱼养殖中,桂建芳团队培育的“中科3号”和“中科5号”占鲫鱼主养区产量的70%左右。这意味着中国人食用的每10条鲫鱼中,就有7条出自水生所桂建芳团队。
桂建芳还将新品种免费赠送给湖北、广东、江苏等地的苗种繁殖场,并上门进行苗种繁育技术指导,奔赴全国各地开展养殖技术培训。银鲫新品种的广泛养殖,加快了中国鲫鱼种业和产业的发展速度。1983年,中国鲫鱼总产量为4.8万吨,2021年这个数字变成了278.4万吨。

02
致力于解决“吃鲫鱼,挑刺儿难”的问题
鲫鱼炖汤味道鲜美,富有营养价值。然而,鲫鱼身上的小刺儿最多可达到八十多根,在水生物领域被称为肌间刺,这成为了人们对鲫鱼鱼肉望而却步的原因。
为了解决“吃鲫鱼挑刺儿难”的问题,桂建芳团队通过基因编辑技术,找到并敲除了控制鲫鱼生长肌间刺的基因功能。他们与华中农业大学水产学院的高泽霞教授合作,经过两年研究,已经筛选出200多条无肌间刺的银鲫,下一步将进行大量繁育。
肌间刺被敲掉了,会不会影响其他的基因性状?是不是安全?影不影响食用的味道?桂建芳表示,这些都要通过后期试验进行比较分析、得出结论。
“基因编辑,就像修改文章,把基因做剪辑或者修饰,让它不发挥作用,肌间刺就长不出来了。基因编辑技术比20年前的基因转移、基因工程更安全,技术本身给有机体的改变更少,这种改变又更加定向、有效。”桂建芳说。

桂建芳表示,遗传育种技术目前在农业、医学等领域均获得了较快的应用。“一个技术,你没有抢占到制高点,你发展得慢了,意味着你就落后了,中国的(技术)绝对不能落后。”

作为较为安全的动物蛋白来源,鱼类等水产品的供应对全球食品安全起到至关重要的作用。近20年来,世界水产品养殖产量近60%来自中国。在桂建芳看来,新时代“可持续发展”和“生态文明建设”驱动下的水产养殖技术和养殖模式的重大转变,向世界贡献了耕海牧渔的中国智慧。
专注鱼类育种40年
只为“让每个中国人都吃得起鱼”
向桂建芳院士致敬!
